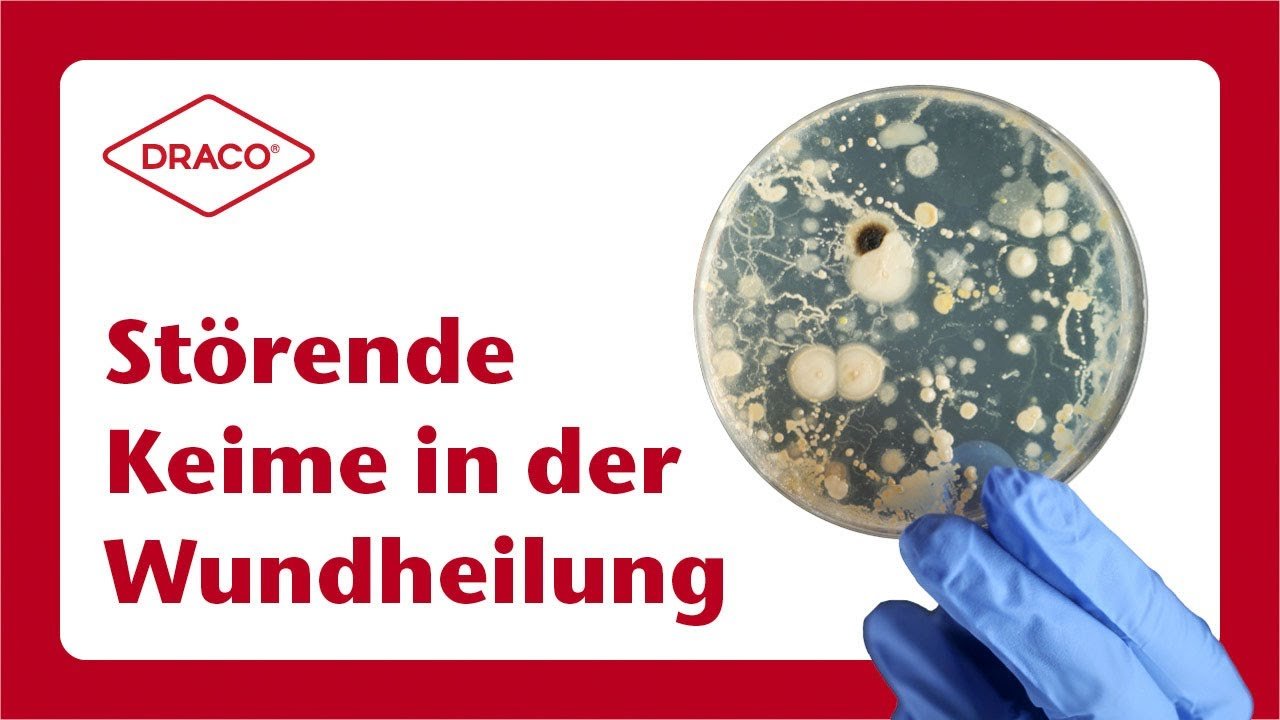
Video Thumbnail Störende Keime in der Wundheilung

Experten-News | DRACO
Herzlich willkommen zu unserem Videoblog!
In unseren 5-minütigen Videos möchten wir kurz und prägnant wichtige und aktuelle Themen aus der Medizinbranche, insbesondere der Wundversorgung, besprechen. Informieren Sie sich schnell und unkompliziert über wichtigste Fakten, aktuelle Neuigkeiten und interessante Themen.
Schauen Sie regelmäßig vorbei und entdecken Sie unser neuestes Video!
Aktuelle Folge: Madentherapie
Bei Start des Videos werden Informationen an YouTube/Google übermittelt. Mehr hierzu unter: Google Datenschutzerklärung.
Versorgung von iatrogenen Wunden
Narben verhindern & Narben pflegen
5 Tipps zum Ausbildungsstart der MFA
Die Haut im Sommer
Schweigepflicht in der Arztpraxis
Versorgung von tiefen Schnittwunden
Störende Keime in der Wundheilung
Diabetischer Fuß – 3 Hilfsmaterialien
Erste Hilfe im Praxisalltag
Diese und alle anderen Episoden des Videoblogs finden Sie auf unserem YouTube-Kanal. Schauen Sie doch gleich mal vorbei!
Sie haben Anregungen, Themenwünsche oder Fragen? Schreiben Sie uns gerne jederzeit an videoblog@draco.de.